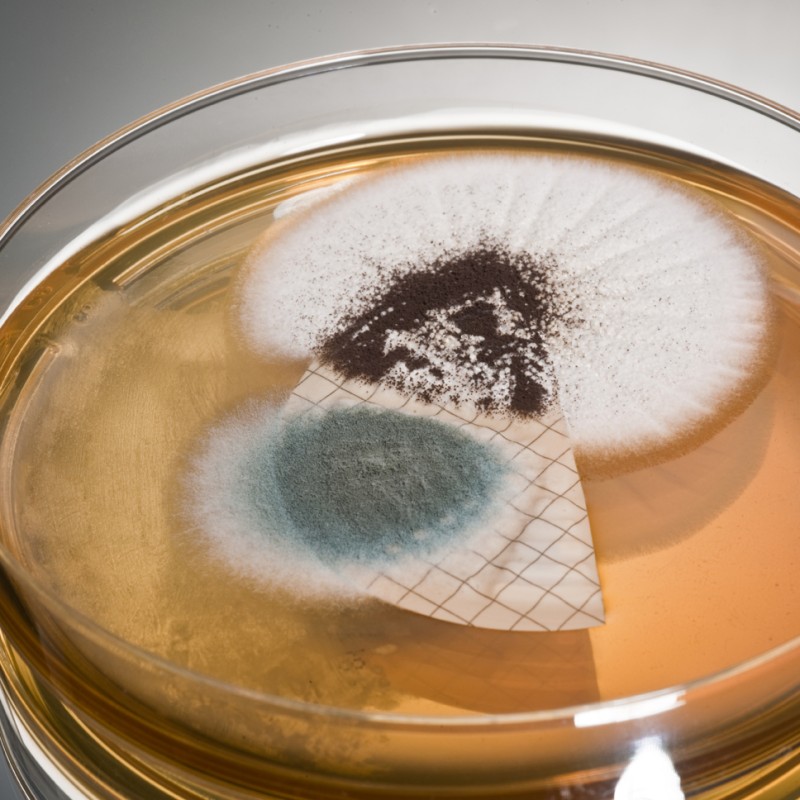

Marine Analysis Program
Microbiological Test
Sterile membranes are used to filter the fluid and these are then placed on a suitable growth medium and allowed to incubate. After 5 days, they are assessed for growth. Fuel samples are tested for the presence of viable fungal spores and aerobic bacteria. The presence of a high content of aerobic bacteria in an otherwise microorganism free sample often indicates that the environment may soon become favourable for further microbiological activity. Slight water contamination favours the self-perpetuating environment of the fungus Hormoconis resinae. This fungus forms dense mycelial mats which break up and move through the fuel system causing numerous operational problems. In addition, these mats release organic acids and produce a highly oxygenated environment which can favour electrolytic attack of metals, even penetrating tank coatings, consume O-rings and rubber hosing. Our method for the detection of viable microorganisms in hydrocarbon fuels follows the Institute of Petroleum Standard Method.
BACK